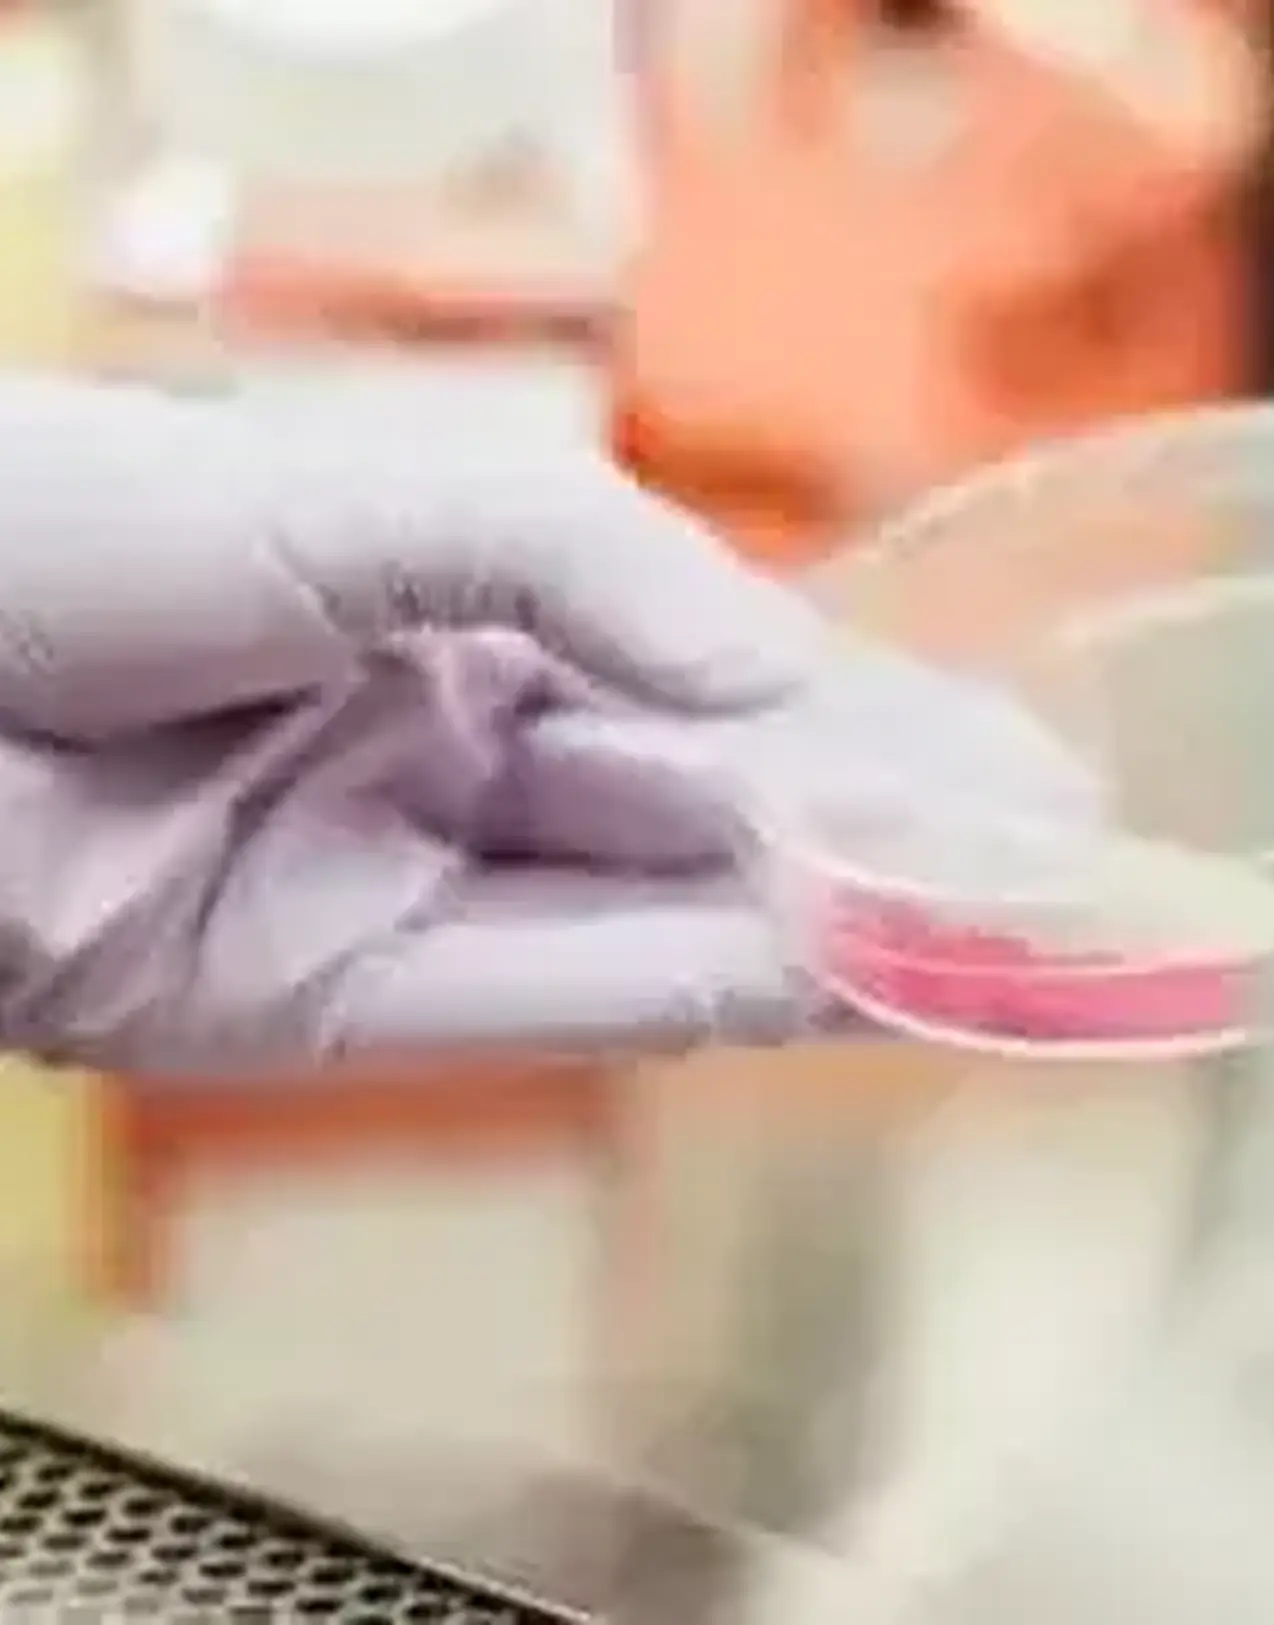
Can i fly on a regular flight

Can I fly on a regular flight with an infectious disease or do I need an air ambulance?
If you contract an infectious disease while abroad, or were hoping to fly out of the country, but have caught a contagious virus or bacteria, you might be wondering if you need to reconsider your travel plans. Depending on certain factors, though, it might still be possible to make your original flight and avoid the need for an air ambulance.
Research has shown that the risk of any infectious disease being transmitted on board an aircraft is very small. The quality of the aircraft cabin air is carefully controlled. Transmission of infection can occur between passengers who are seated in the same area of an aircraft, for example through a cough or sneeze, or by touch. This is no different from being close to someone in any other form of transport such as a bus or train. In order to minimise the risk of passing infections in an aircraft, passengers who are actively unwell, especially if they have a fever, should delay travel until they have recovered.
Different airlines have different policies
Airlines can refuse travel to a passenger, if they suspect they may be contagious. It is worth checking your airline’s policy and possibly contacting them before travelling to the airport. There are several conditions, such as rubella, measles or mumps, that require a medical certificate before you are allowed to fly. This is even true when you have recovered from the disease but are still showing symptoms, such as spots following chicken pox. In such cases it’s worth carrying a letter from their GP confirming that you are fit-to-fly, to make sure you are allowed on the plane.
In general, airlines take infection risk very seriously and where an individual has travelled and is subsequently found to have been carrying a serious infectious illness with potential risks to other passengers, contact tracing of passengers will be carried out by public health authorities.
How can I get home if I’m not allowed to fly?
If you’ve been denied passage on a flight, there are many reasons why you might still want to get home as soon as possible. Maybe there are medical reasons: the treatment you need is not available or you are unhappy with the level of care at the local hospital. Or you might simply want to be closer to family and friends as you recover. Medical transport companies like EMS can help you get home wherever you are. At EMS we have our own fleet of ICU equipped road ambulances that allow us to repatriate patients over long distances, even outside the borders of Europe. If you do need to travel by plane, we can arrange a private air ambulance for you. Our medical team will travel to you, pick you up and accompany you on your way home to make sure you receive all the care you need.
Contact
If you have any questions on how to get home, be it by road ambulance or private air ambulance, or just want to discuss your situation and chat through the options, don’t hesitate to get in touch either by phone, email or through our online chat function. We are here to help you get back home safely!
Related blogs







